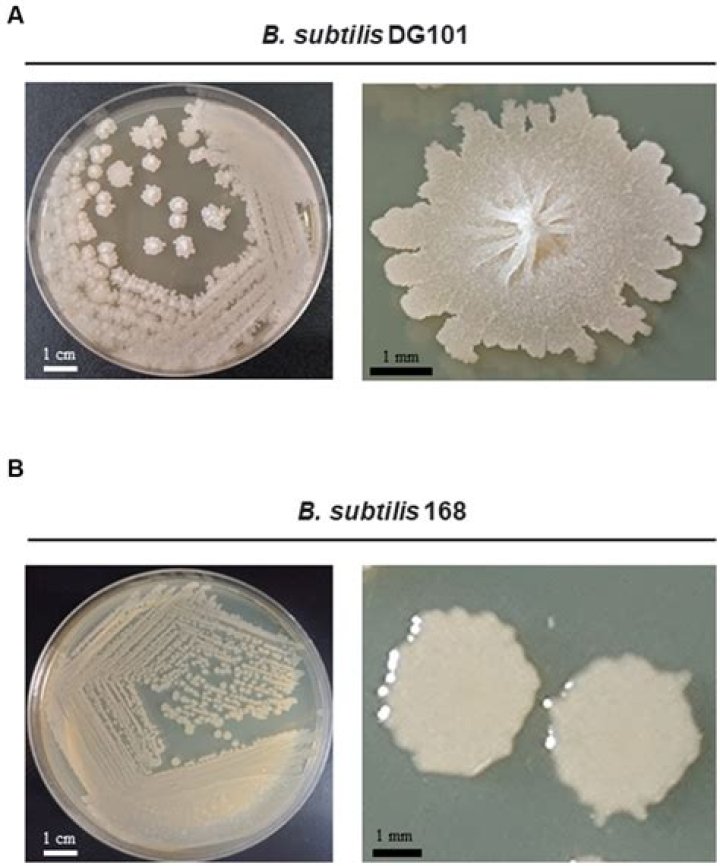

Does bacillus subtilis grow on msa?
When the Bacillus subtilis was isolated on the Mannitol Salt Agar plate, the color of the plate also changed from red to yellow. ... Bacillus subtilis is not able to ferment mannitol and yet the Mannitol test yielded a positive result.
Does Bacillus grow in MSA?
Some group D enterococci may exhibit growth with mannitol fermentation; however, catalase test and gram morphology should distinguish between enterococci and staphylococci. Prolonged incubation (≥ 48 hours) may also allow growth of Micrococcus, Bacillus, and some species of Serratia.
What media does Bacillus subtilis grow on?
Bacillus subtilis can grow in any medium containing nitrogen and carbon source with Nacl.
What grows on mannitol salt agar?
Staphylococcus aureus and Staphylococcus epidermidis on mannitol salt agar. Mannitol salt agar is a commonly used growth medium in microbiology. ... Staphylococcus aureus produce yellow colonies with yellow zones, whereas other Staphylococci produce small pink or red colonies with no colour change to the medium.
Can salmonella grow on MSA?
Bile salts and crystal violet inhibits the growth of most Gram positive, non-enteric bacteria. Gram negative enteric bacilli will grow; E. coli will produce pink colonies, Salmonella and Shigella spp. ... cereus does not ferment mannitol and colonies are deep red.
How to Grow Bacillus Subtilis
40 related questions foundWhat makes MSA selective?
Mannitol Salt Agar (MSA) is a selective and differential medium. The high concentration of salt (7.5%) selects for members of the genus Staphylococcus, since they can tolerate high saline levels. ... The Staphylococcus aureus ferments mannitol and turns the medium yellow.
What does Bacillus subtilis look like on an agar plate?
Bacillus subtilis is a typical germ, which is rod-shaped and Gram-positive. When cultured on ordinary nutrient agar, the morphology circular colony of this bacteria is rough, opaque, fuzzy white or slightly yellow with jagged edges [1, 7].
What does Bacillus subtilis need to grow?
Bacillus subtilis grow in the mesophilic temperature range. The optimal temperature is 25-35 degrees Celsius (Entrez Genome Project). Stress and starvation are common in this environment, therefore, Bacillus subtilis has evolved a set of strategies that allow survival under these harsh conditions.
Is Bacillus subtilis anaerobic or aerobic?
The Gram-positive soil bacterium Bacillus subtilis, generally regarded as an aerobe, grows under strict anaerobic conditions using nitrate as an electron acceptor and should be designated as a facultative anaerobe.
What ingredient makes MSA differential?
The differential ingredient in MSA is the sugar mannitol. Organisms capable of using mannitol as a food source will produce acidic byproducts of fermentation that will lower the pH of the media. The acidity of the media will cause the pH indicator, phenol red, to turn yellow.
What does growth on MSA plate mean?
Mannitol Salt Agar (MSA) is used to determine if the bacteria is halophilic (salt loving) and if the bacteria can ferment mannitol. If the bacteria is able to grow then it is a halophilic bacteria, due to it's ability to grow in a high salt environment.
Does Streptococcus grow on MSA?
MSA contains a high concentration of salt (NaCl), and therefore, selects for the growth of microbes that can tolerate high salt concentrations. Staphylococcus species are halotolerant, whereas Streptococcus species and many other organisms are inhibited by high concentrations of NaCl.
Does Bacillus subtilis ferment glucose?
subtilis cannot ferment either glucose or pyruvate efficiently (unlike E. coli) and why pyruvate enhances glucose fermentation are unknown. NMR analysis showed that fermentation products in B. subtilis include acetate, acetoin, ethanol, lactate, succinate and 2,3-butanediol, indicating a mixed acid fermentation [10].
What does no growth on MSA plate mean?
Selective medium
MSA helps to demonstrate the ability of a bacterium to grow in a 7.5% salt environment (growth indicates tolerance for a high salt environment – no growth means intolerance). Species of staphylococci are able to tolerate this salt concentration but other pathogenic bacteria may not.
How does Bacillus subtilis reproduce?
B. subtilis can divide symmetrically to make two daughter cells (binary fission), or asymmetrically, producing a single endospore that can remain viable for decades and is resistant to unfavourable environmental conditions such as drought, salinity, extreme pH, radiation, and solvents.
How fast does Bacillus subtilis grow?
Their colour is white and dull and they have a dry texture. The prefered medium of Bacillus subtilis is LB medium. The growth follows the typical four phases of bacterial growth (figure 2) and with reaching the exponential growth phase, Bacillus subtilis has a doubling time of 30 minutes under ideal conditions.
What is unique about Bacillus subtilis?
Bacillus subtilis is one of the best characterized bacteria and is used as a model organism for Gram-positive bacteria. ... subtilis is a rod-shaped bacterium, which produces endospores that allow the survival of extreme environmental conditions including heat and desiccation.
Does Bacillus subtilis turn MSA yellow?
When the Bacillus subtilis was isolated on the Mannitol Salt Agar plate, the color of the plate also changed from red to yellow. ... Bacillus subtilis is not able to ferment mannitol and yet the Mannitol test yielded a positive result.
How do you find Bacillus subtilis?
Bacillus subtilis is a spore forming, motile, rod-shaped, Gram-positive, facultative aerobe. It is mostly found in soil and vegetation with an optimal growth temperature from 25-35 degrees Celsius.
Where do I find Bacillus subtilis?
subtilis) is a Gram-positive, aerobic bacterium. It is rod-shaped and catalase-positive. B. subtilis is found in soil and the gastrointestinal tract of ruminants and humans.
What is found within MSA media that inhibits the growth of most bacteria?
It contains a high concentration (about 7.5–10%) of salt (NaCl) which is inhibitory to most bacteria - making MSA selective against most Gram-negative and selective for some Gram-positive bacteria (Staphylococcus, Enterococcus and Micrococcaceae) that tolerate high salt concentrations.
How are MSA and Mac both selective and differential?
The MacConkey's and Mannitol Salt described above are both selective and differential bacterial growth media. metabolize the sugar lactose) to grow in pink colonies, whereas Gram-negative non-lactose fermenting bacteria will grow in colorless colonies. ... This medium only grows salt-loving bacteria (so it is selective).
Can Listeria grow on mannitol salt agar?
Listeria monocytogenes hydrolyses aesculin resulting in the formation of a black halo around colonies. Listeria monocytogenes does not ferment mannitol so easy differentiation from contaminants, such as enterococci and staphylococci, can be made as these will ferment mannitol.



